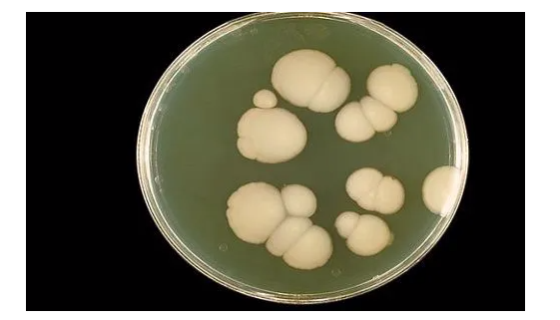
白色念珠菌的特征与生存环境及在DYMD系统的位置！
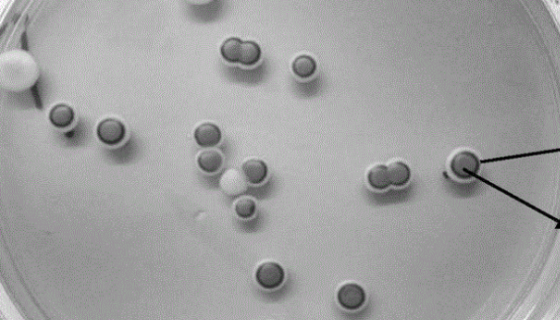
乳酸克鲁维酵母的生命周期与能量代谢及工业应用！

生孢梭菌的主要应用与治疗作用及实验研究!
生孢梭菌(Clostridium sporogenes)又译...

MLE-12小鼠肺上皮细胞的培养操作与应用!
MLE-12小鼠肺上皮细胞 是由Kathryn A.Wike...
白色念珠菌的特征与生存环境及在DYMD系统的位置!
白假丝酵母菌(candida Albicans)又称白色念珠...

大鼠内皮祖细胞永生化的运输和保存及使用!
大鼠内皮祖细胞永生化的特性与使用方法及培养注意事项。

普通变形杆菌的生物与病理特性及预防与治疗!
普通变形杆菌属于变形杆菌属(Proteus),广泛存在于水、...
乳酸克鲁维酵母的生命周期与能量代谢及工业应用!
乳酸克鲁维酵母是生物技术科学领域非常重要的非酿酒酵母之一,其...

大鼠脑微血管内皮细胞的体外培养及相关研究!
大鼠脑微血管内皮细胞的特性与使用及体外培养与相关研究!

阴道乳杆菌的主要种群异同与健康研究!
乳杆菌是健康育龄女性阴道的主要菌群。早期认为,阴道主要的乳杆...

变异链球菌的感染源及其微生态学研究进展!
变异链球菌属于甲型溶血性链球菌类,菌体较小,呈圆形或卵圆形,...